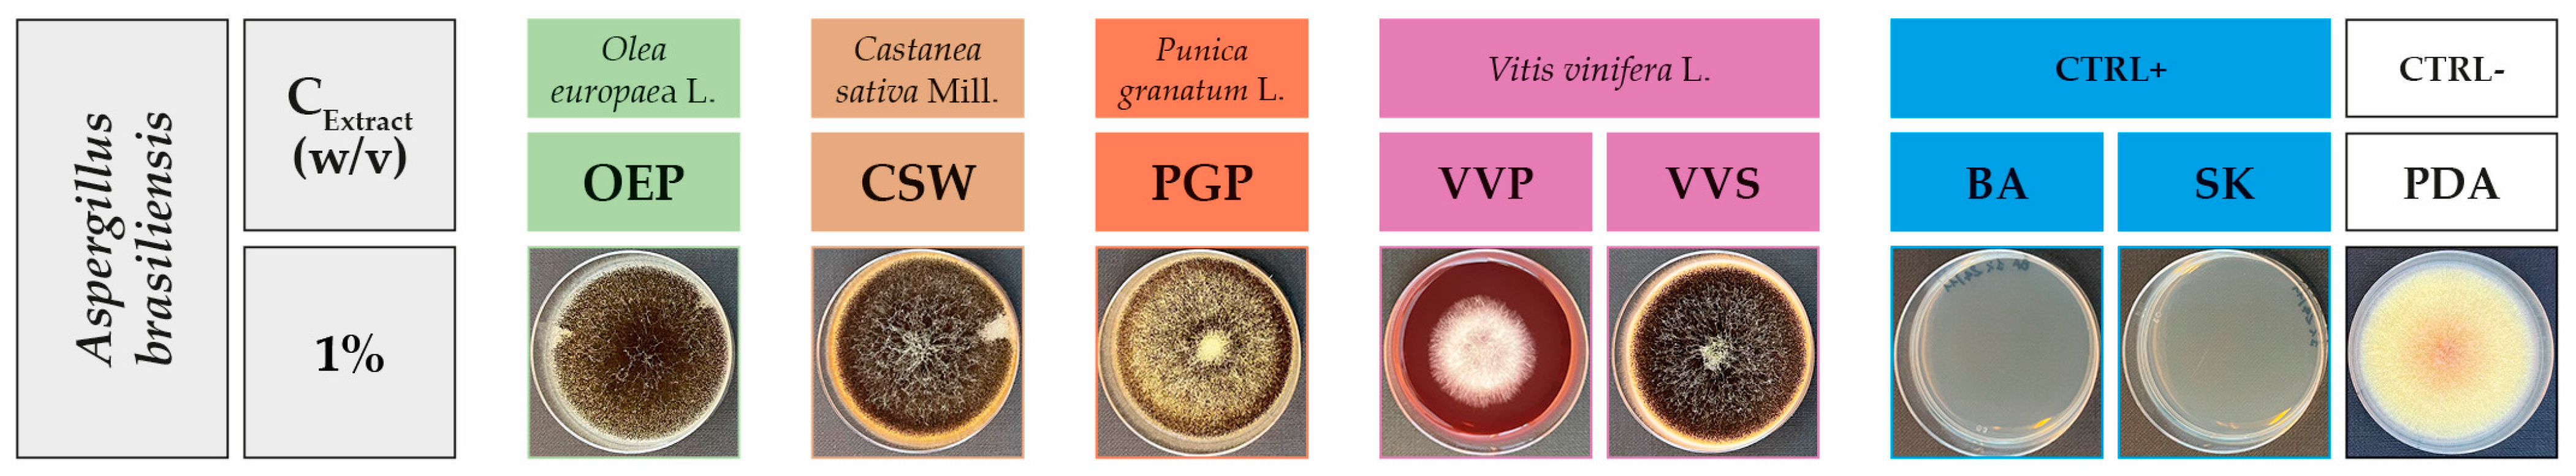

Phenolic-Rich Extracts from Circular Economy: Chemical Profile and Activity against Filamentous Fungi and Dermatophytes
Abstract
1. Introduction
2. Results and Discussion
2.1. Phenolic-Rich Extracts
2.2. Antifungal Activity
3. Materials and Methods
3.1. Chemicals
3.2. Phenolic-Rich Extracts
3.3. Characterization of Phenolic-Rich Extracts
3.4. Fungal Pathogens
3.5. In Vitro Antifungal Activity Assay
3.6. Statistical Analysis
4. Conclusions
Supplementary Materials
Author Contributions
Funding
Institutional Review Board Statement
Informed Consent Statement
Data Availability Statement
Acknowledgments
Conflicts of Interest
Sample Availability
References
- Avery, S.V.; Singleton, I.; Magan, N.; Goldman, G.H. The fungal threat to global food security. Fungal Biol. 2019, 123, 555–557. [Google Scholar] [CrossRef] [PubMed]
- Fisher, M.C.; Gurr, S.J.; Cuomo, C.A.; Blehert, D.S.; Jin, H.; Stukenbrock, E.H.; Stajich, J.E.; Kahmann, R.; Boone, C.; Denning, D.W.; et al. Threats posed by the fungal kingdom to humans, wildlife, and agriculture. mBio 2020, 11, e00449-20. [Google Scholar] [CrossRef] [PubMed]
- Mahato, D.K.; Lee, K.E.; Kamle, M.; Devi, S.; Dewangan, K.N.; Kumar, P.; Kang, S.G. Aflatoxins in food and feed: An overview on prevalence, detection and control strategies. Front. Microbiol. 2019, 10, 2266. [Google Scholar] [CrossRef] [PubMed]
- Alkan, N.; Fortes, A.M. Insights into molecular and metabolic events associated with fruit response to post-harvest fungal pathogens. Front. Plant Sci. 2015, 6, 889. [Google Scholar] [CrossRef] [PubMed]
- Hoffmann, S.; Scallan, E. Chapter 2-Epidemiology, cost, and risk analysis of foodborne disease. In Foodborne Diseases, 3rd ed.; Dodd, C.E.R., Aldsworth, T., Stein, R.A., Cliver, D.O., Riemann, H.P., Eds.; Academic Press: Cambridge, MA, USA, 2017; pp. 31–63. [Google Scholar]
- Granja, N.; Domingues, P.; Cabecinhas, M.; Zimon, D.; Sampaio, P. ISO 22000 Certification: Diffusion in Europe. Resources 2021, 10, 100. [Google Scholar] [CrossRef]
- ISO 22000:2018; Food Safety Management Systems—Requirements for Any Organization in the Food Chain. International Organization for Standardization: Geneva, Switzerland, 2018. Available online: https://www.iso.org/standard/65464.html (accessed on 24 March 2023).
- ISO 21257-1:2008; Microbiology of Food and Animal Feeding Stuffs—Horizontal Method for the Enumeration of Yeasts and Moulds—Part 1: Colony Count Technique in Products with Water Activity Greater than 0,95. International Organization for Standardization: Geneva, Switzerland, 2008. Available online: https://www.iso.org/standard/38275.html (accessed on 24 March 2023).
- ISO 21257-2:2008; Microbiology of Food and Animal Feeding Stuffs—Horizontal Method for the Enumeration of Yeasts and Moulds—Part 2: Colony Count Technique in Products with Water Activity Less than or Equal to 0,95. International Organization for Standardization: Geneva, Switzerland, 2008. Available online: https://www.iso.org/standard/38276.html (accessed on 24 March 2023).
- Kousha, M.; Tadi, R.; Soubani, A.O. Pulmonary Aspergillosis: A clinical review. Eur. Respir. Rev. 2011, 20, 156–174. [Google Scholar] [CrossRef]
- Lehmann, S.; Sprünken, A.; Wagner, N.; Tenbrock, K.; Ott, H. Clinical relevance of IgE-mediated sensitization against the mould Alternaria alternata in children with asthma. Ther. Adv. Respir. Dis. 2017, 11, 30–39. [Google Scholar] [CrossRef]
- Segal, E.; Elad, D. Human and zoonotic dermatophytoses: Epidemiological aspects. Front. Microbiol. 2021, 12, 713532. [Google Scholar] [CrossRef]
- Garvey, M.; Rowan, N.J. Pathogenic drug resistant fungi: A review of mitigation strategies. Int. J. Mol. Sci. 2023, 24, 1584. [Google Scholar] [CrossRef]
- Bernini, R.; Mincione, E.; Barontini, M.; Fabrizi, G.; Pasqualetti, M.; Tempesta, S. Convenient oxidation of alkylated phenols and methoxytoluenes to antifungal 1,4-benzoquinones with hydrogen peroxide/methyltrioxorhenium catalytic system in neutral ionic liquid. Tetrahedron 2006, 62, 7733–7737. [Google Scholar] [CrossRef]
- Bernini, R.; Mincione, E.; Provenzano, G.; Fabrizi, G.; Tempesta, S.; Pasqualetti, M. Obtaining new flavanones exhibiting antifungal activities by methyltrioxorhenium-catalyzed epoxidation-methanolysis of flavones. Tetrahedron 2008, 64, 7561–7566. [Google Scholar] [CrossRef]
- Bernini, R.; Pasqualetti, M.; Provenzano, G.; Tempesta, S. Ecofriendly synthesis of halogenated flavonoids and evaluation of their antifungal activity. New J. Chem. 2015, 39, 2980–2987. [Google Scholar] [CrossRef]
- Lombardi, A.; Fochetti, A.; Vignolini, P.; Campo, M.; Durazzo, A.; Lucarini, M.; Puglia, D.; Luzi, F.; Papalini, M.; Renzi, M.; et al. Natural active ingredients for poly (lactic acid)-based materials: State of the art and perspectives. Antioxidants 2022, 11, 2074. [Google Scholar] [CrossRef]
- Dewick, P.M. Medicinal Natural Products: A Biosynthetic Approach, 3rd ed.; Dewick, P.M., Ed.; John Wiley & Sons, Ltd.: Chichester, UK, 2009. [Google Scholar]
- Sun, W.; Shahrajabian, M.H. Therapeutic potential of phenolic compounds in medicinal plants. Natural health products for human health. Molecules 2023, 28, 1845. [Google Scholar] [CrossRef] [PubMed]
- Roma, E.; Mattoni, E.; Lupattelli, P.; Moeini, S.S.; Gasperi, T.; Bernini, R.; Incerpi, S.; Tofani, D. New dihydroxytyrosyl esters from dicarboxylic acids. Synthesis and evaluation of the antioxidant activity in vitro (ABTS) and in cell-cultures (DCF assay). Molecules 2020, 25, 3135. [Google Scholar] [CrossRef]
- Bernini, R.; Velotti, F. Natural polyphenols as immunomodulators to rescue immune response homeostasis: Quercetin as a research model against severe COVID-19. Molecules 2021, 26, 5803. [Google Scholar] [CrossRef] [PubMed]
- Luzi, F.; Pannucci, E.; Clemente, M.; Grande, E.; Urciuoli, S.; Romani, A.; Torre, L.; Puglia, D.; Bernini, R.; Santi, L. Hydroxytyrosol and oleuropein-enriched extracts obtained from olive oil wastes and by-products as active antioxidant ingredients for poly(vinyl alcohol)-based films. Molecules 2021, 26, 2104. [Google Scholar] [CrossRef]
- Laghezza Masci, V.; Bernini, R.; Villanova, N.; Clemente, M.; Cicaloni, V.; Tinti, L.; Salvini, L.; Taddei, A.R.; Tiezzi, A.; Ovidi, E. In vitro anti-proliferative and apoptotic effects of hydroxytyrosyl oleate on SH-SY5Y human neuroblastoma cells. Int. Mol. J. Sci. 2022, 23, 12348. [Google Scholar] [CrossRef]
- Pinto, G.; De Pascale, S.; Aponte, M.; Scaloni, A.; Addeo, F.; Caira, S. Polyphenol profiling of chestnut pericarp, integument and curing water extracts to qualify these food by-products as a source of Antioxidants. Molecules 2021, 26, 2335. [Google Scholar] [CrossRef] [PubMed]
- Romani, A.; Ieri, F.; Urciuoli, S.; Noce, A.; Marrone, G.; Nediani, C.; Bernini, R. Health Effects of Phenolic Compounds Found in Extra-Virgin Olive Oil, By-Products, and Leaf of Olea europaea L. Nutrients 2019, 11, 1776. [Google Scholar] [CrossRef]
- Lucarini, M.; Durazzo, A.; Bernini, R.; Campo, M.; Vita, C.; Souto, E.B.; Lombardi-Boccia, G.; Ramadan, M.F.; Santini, A.; Romani, A. Fruit wastes as valuable source of value-added compounds: A collaborative perspective. Molecules 2021, 26, 6338. [Google Scholar] [CrossRef]
- Goufo, P.; Singh, R.K.; Cortez, I. A Reference list of phenolic compounds (including stilbenes) in grapevine (Vitis vinifera L.) roots, woods, canes, stems, and leaves. Antioxidants 2020, 9, 398. [Google Scholar] [CrossRef]
- Stahel, W.R. The circular economy. Nature 2016, 531, 435–438. [Google Scholar] [CrossRef] [PubMed]
- Rodis, P.S.; Karathanos, V.T.; Mantzavinou, A. Partitioning of olive oil antioxidants between oil and water phases. J. Agric. Food Chem. 2002, 50, 596–601. [Google Scholar] [CrossRef] [PubMed]
- Aliaño-González, M.J.; Gabaston, J.; Ortiz-Somovilla, V.; Cantos-Villar, E. Wood Waste from Fruit Trees: Biomolecules and Their Applications in Agri-Food Industry. Biomolecules 2022, 12, 238. [Google Scholar] [CrossRef]
- Echegaray, N.; Gómez, B.; Barba, F.J.; Franco, D.; Estévez, M.; Carballo, J.; Marszałek, K.; Lorenzo, J.M. Chestnuts and by-products as source of natural antioxidants in meat and meat products: A review. Trends Food Sci. Technol. 2018, 82, 110–121. [Google Scholar] [CrossRef]
- Jurenka, J. Therapeutic applications of pomegranate (Punica granatum L.): A review. Altern. Med. Rev. 2008, 13, 128–144. [Google Scholar]
- Nuamsetti, T.; Dechayuenyong, P.; Tantipaibulvut, S. Antibacterial activity of pomegranate fruit peels and arils. Sci. Asia 2012, 38, 319–322. [Google Scholar] [CrossRef]
- Dwyer, K.; Hosseinian, F.; Rod, M. The market potential of grape waste alternatives. J. Food Res. 2014, 3, 91–96. [Google Scholar] [CrossRef]
- Lucarini, M.; Durazzo, A.; Romani, A.; Campo, M.; Lombardi-Boccia, G.; Cecchini, F. Bio-based compounds from grape seeds: A biorefinery approach. Molecules 2018, 23, 1888. [Google Scholar] [CrossRef]
- Ky, I.; Teissedre, P.-L. Characterisation of Mediterranean Grape Pomace Seed and Skin Extracts: Polyphenolic Content and Antioxidant Activity. Molecules 2015, 20, 2190–2207. [Google Scholar] [CrossRef]
- Campo, M.; Pinelli, P.; Romani, A. Hydrolyzable tannins from sweet chestnut fractions obtained by a sustainable and eco-friendly industrial process. Nat. Prod. Commun. 2016, 11, 1934578X1601100. [Google Scholar] [CrossRef]
- Romani, A.; Campo, M.; Urciuoli, S.; Marrone, G.; Noce, A.; Bernini, R. An industrial and sustainable platform for the production of bioactive micronized powders and extracts enriched in polyphenols from Olea europaea L. and Vitis vinifera L. wastes. Front. Nutr. 2020, 7, 120. [Google Scholar] [CrossRef] [PubMed]
- Feldman, K.S.; Smith, R.S. Ellagitannin chemistry. First total synthesis of the 2, 3-and 4, 6-coupled ellagitannin pedunculagin. J. Org. Chem. 1996, 61, 2606–2612. [Google Scholar] [CrossRef]
- Yamada, H.; Wakamori, S.; Hirokane, T.; Ikeuchi, K.; Matsumoto, S. Structural revisions in natural ellagitannins. Molecules 2018, 23, 1901. [Google Scholar] [CrossRef]
- Karaseva, V.; Bergeret, A.; Lacoste, C.; Ferry, L.; Fulcrand, H. Influence of extraction conditions on chemical composition and thermal properties of chestnut wood extracts as tannin feedstock. ACS Sustain. Chem. Eng. 2019, 7, 17047–17054. [Google Scholar] [CrossRef]
- Moccia, F.; Flores-Gallegos, A.C.; Chávez-González, M.L.; Sepúlveda, L.; Marzorati, S.; Verotta, L.; Panzella, L.; Ascacio-Valdes, J.A.; Aguilar, C.N.; Napolitano, A. Ellagic acid recovery by solid state fermentation of pomegranate wastes by Aspergillus niger and Saccharomyces cerevisiae: A comparison. Molecules 2019, 24, 3689. [Google Scholar] [CrossRef]
- Funatogawa, K.; Hayashi, S.; Shimomura, H.; Yoshida, T.; Hatano, T.; Ito, H.; Hirai, Y. Antibacterial activity of hydrolyzable tannins derived from medicinal plants against Helicobacter pylori. Microbiol. Immunol. 2004, 48, 251–261. [Google Scholar] [CrossRef]
- Côté, J.; Caillet, S.; Doyon, G.; Sylvain, J.F.; Lacroix, M. Bioactive compounds in cranberries and their biological properties. Crit. Rev. Food Sci. Nutr. 2010, 50, 666–679. [Google Scholar] [CrossRef]
- Romani, A.; Campo, M.; Pinelli, P. HPLC/DAD/ESI-MS analyses and anti-radical activity of hydrolyzable tannins from different vegetal species. Food Chem. 2012, 130, 214–221. [Google Scholar] [CrossRef]
- Lee, H.B.; Patriarca, A.; Magan, N. Alternaria in Food: Ecophysiology, Mycotoxin Production and Toxicology. Mycobiology 2015, 43, 93–106. [Google Scholar]
- Patriarca, A. Alternaria in Food Products. Curr. Opin. Food Sci. 2016, 11, 1–9. [Google Scholar] [CrossRef]
- Tralamazza, S.M.; Piacentini, K.C.; Iwase, C.H.T.; Rocha, L.d.O. Toxigenic Alternaria Species: Impact in Cereals Worldwide. Curr. Opin. Food Sci. 2018, 23, 57–63. [Google Scholar] [CrossRef]
- Arcella, D.; Eskola, M.; Gómez Ruiz, J.A.; EFSA (European Food Safety Authority). Scientific report on the dietary exposure assessment to Alternaria toxins in the European population. EFSA J. 2016, 14, 4654. [Google Scholar]
- Varga, J.; Kocsubé, S.; Tóth, B.; Frisvad, J.C.; Perrone, G.; Susca, A.; Meijer, M.; Samson, R.A. Aspergillus brasiliensis sp. nov., a biseriate black Aspergillus species with world-wide distribution. Int. J. Syst. Evol. Microbiol. 2007, 57, 1925–1932. [Google Scholar] [CrossRef] [PubMed]
- Nielsen, K.F.; Mogensen, J.M.; Johansen, M.; Larsen, T.O.; Frisvad, J.C. Review of secondary metabolites and mycotoxins from the Aspergillus niger group. Anal. Bioanal. Chem. 2009, 395, 1225–1242. [Google Scholar] [CrossRef]
- Tyski, S.; Bocian, E.; Laudy, A.E. Application of normative documents for determination of biocidal activity of disinfectants and antiseptics dedicated to the medical area: A narrative review. J. Hosp. Infect. 2022, 125, 75–91. [Google Scholar] [CrossRef]
- Racchi, I.; Scaramuzza, N.; Hidalgo, A.; Cigarini, M.; Berni, E. Sterilization of food packaging by UV-C irradiation: Is Aspergillus brasiliensis ATCC 16404 the best target microorganism for industrial bio-validations? Int. J. Food Microbiol. 2021, 357, 109383. [Google Scholar] [CrossRef]
- Bautista-Baños, S.; Bosquez-Molina, E.; Barrera-Necha, L.L. Rhizopus stolonifer (soft rot). In Postharvest Decay Control Strategies, 1st ed.; Bautista-Baños, S., Ed.; Elsevier Inc.: London, UK, 2014; Chapter 1; pp. 1–37. [Google Scholar]
- Tang, C.; Kong, X.; Ahmed, S.A.; Thakur, R.; Chowdhary, A.; Nenoff, P.; Uhrlass, S.; Verma, S.B.; Meis, J.F.; Kandemir, H.; et al. Taxonomy of the Trichophyton mentagrophytes/T. interdigitale Species Complex Harboring the Highly Virulent, Multiresistant Genotype T. indotineae. Mycopathologia 2021, 186, 315–326. [Google Scholar] [CrossRef]
- Jazdarehee, A.; Malekafzali, L.; Lee, J.; Lewis, R.; Mukovozov, I. Transmission of onychomycosis and dermatophytosis between household members: A Scoping Review. JoF 2022, 8, 60. [Google Scholar] [CrossRef]
- Yazdanpanah, S.; Sasanipoor, F.; Khodadadi, H.; Rezaei-Matehkolaei, A.; Jowkar, F.; Zomorodian, K.; Kharazi, M.; Mohammadi, T.; Nouripour-Sisakht, S.; Nasr, R.; et al. Quantitative analysis of in vitro biofilm formation by clinical isolates of dermatophyte and antibiofilm activity of common antifungal drugs. Int. J. Dermatol. 2023, 62, 120–127. [Google Scholar] [CrossRef] [PubMed]
- Kinay, P.; Mansour, M.F.; Mlikota Gabler, F.; Margosan, D.A.; Smilanick, J.L. Characterization of fungicide-resistant isolates of Penicillium digitatum collected in California. Crop Prot. 2007, 26, 647–656. [Google Scholar] [CrossRef]
- Achar, P.N.; Quyen, P.; Adukwu, E.C.; Sharma, A.; Msimanga, H.Z.; Nagaraja, H.; Sreenivasa, M.Y. Investigation of the Antifungal and Anti-Aflatoxigenic Potential of Plant-Based Essential Oils against Aspergillus flavus in Peanuts. J. Fungi 2020, 6, 383. [Google Scholar] [CrossRef] [PubMed]
- Touba, E.P.; Zakaria, M.; Tahereh, E. Anti-fungal activity of cold and hot water extracts of spices against fungal pathogens of Roselle (Hibiscus sabdariffa) in vitro. Microb. Pathog. 2012, 52, 125–129. [Google Scholar] [CrossRef]
- Sharma, R.L.; Ahir, R.R.; Yadav, S.L.; Sharma, P.; Ghasolia, R.P. Effect of nutrients and plant extracts on Alternaria blight of tomato caused by Alternaria alternata. J. Plant. Dis. Prot. 2021, 128, 951–960. [Google Scholar] [CrossRef]
- Rafiq, S.; Wagay, N.A.; Elansary, H.O.; Malik, M.A.; Bhat, I.A.; Kaloo, Z.A.; Hadi, A.; Alataway, A.; Dewidar, A.Z.; El-Sabrout, A.M.; et al. Phytochemical screening, antioxidant and antifungal activities of Aconitum Chasmanthum Stapf ex Holmes wild rhizome extracts. Antioxidants 2022, 11, 1052. [Google Scholar] [CrossRef]
- US FDA. Electronic Code of Federal Regulations (eCFR). Substances Generally Recognized as Safe Title 21, Chapter I, Subchapter E, Part 582. Available online: https://www.ecfr.gov/current/title-21/chapter-I/subchapter-E/part-582?toc=1 (accessed on 20 March 2023).
- Commission Regulation (EC) No 1333/2008 of 16 December 2008 on Food Additives (Text with EEA Relevance). Available online: https://eur-lex.europa.eu/legal-content/IT/ALL/?uri=celex%3A32008R1333 (accessed on 28 March 2023).
- Fonseka, S.; Bandara, D.D.J.; Wickramaarachchi, D.C.; Narankotuwa, N.G.K.H.H.; Kumarasiri, P.V.R. Treatment of difficult-to-treat-dermatophytosis: Results of a randomized, double-blind, placebo-controlled study. J. Infect. Dev. Ctries. 2021, 15, 1731–1737. [Google Scholar] [CrossRef]
- El-Gohary, M.; van Zuuren, E.J.; Fedorowicz, Z.; Burgess, H.; Doney, L.; Stuart, B.; Moore, M.; Little, P. Topical antifungal treatments for tinea cruris and tinea corporis. Cochrane Database Syst. Rev. 2014, 8, CD009992. [Google Scholar] [CrossRef]
- Van Diepeningen, A.D.; Debets, A.J.M.; Varga, J.; Van Der Gaag, M.; Swart, K.; Hoekstra, R.F. Efficient degradation of tannic acid by black Aspergillus species. Mycol. Res. 2004, 108, 919–925. [Google Scholar] [CrossRef]
- Kernaghan, G.; Griffin, A.; Gailey, J.; Hussain, A. Tannin tolerance and resistance in dark septate endophytes. Rhizosphere 2022, 23, 100574. [Google Scholar] [CrossRef]
- Ascacio-Valdés, J.A.; Aguilera-Carbó, A.F.; Buenrostro, J.J.; Prado-Barragán, A.; Rodríguez-Herrera, R.; Aguilar, C.N. The complete biodegradation pathway of ellagitannins by Aspergillus niger in solid-state fermentation. J. Basic Microbiol. 2016, 56, 329–336. [Google Scholar] [CrossRef] [PubMed]
- Sampaio, S.L.; Lonchamp, J.; Dias, M.I.; Liddle, C.; Petropoulos, S.A.; Glamoclija, J.; Alexopoulos, A.; Santos-Buelga, C.; Ferreira, I.C.F.R.; Barros, L. Anthocyanin-rich extracts from purple and red potatoes as natural colourants: Bioactive properties, application in a soft drink formulation and sensory analysis. Food Chem. 2021, 342, 128526. [Google Scholar] [CrossRef] [PubMed]
- Esposito, T.; Celano, R.; Pane, C.; Piccinelli, A.L.; Sansone, F.; Picerno, P.; Zaccardelli, M.; Aquino, R.P.; Mencherini, T. Chestnut (Castanea Sativa Miller.) Burs Extracts and Functional Compounds: UHPLC-UV-HRMS Profiling, Antioxidant Activity, and Inhibitory Effects on Phytopathogenic Fungi. Molecules 2019, 24, 302. [Google Scholar] [CrossRef]
- Brighenti, V.; Iseppi, R.; Pinzi, L.; Mincuzzi, A.; Ippolito, A.; Messi, P.; Sanzani, S.M.; Rastelli, G.; Pellati, F. Antifungal Activity and DNA Topoisomerase Inhibition of Hydrolysable Tannins from Punica granatum L. Int. J. Mol. Sci. 2021, 22, 4175. [Google Scholar] [CrossRef] [PubMed]
- Krain, A.; Siupka, P. Fungal guttation, a source of bioactive compounds, and its ecological role—A Review. Biomolecules 2021, 11, 1270. [Google Scholar] [CrossRef] [PubMed]
- Tehranifar, A.; Selahvarzi, Y.; Kharrazi, M.; Bakhsh, V.J. High potential of agro-industrial by-products of pomegranate (Punica granatum L.) as the powerful antifungal and antioxidant substances. Ind. Crop. Prod. 2011, 34, 1523–1527. [Google Scholar] [CrossRef]
- Markin, D.; Duek, L.; Berdicevsky, I. In vitro antimicrobial activity of olive leaves. Antimikrobielle Wirksamkeit von Olivenblättern in vitro. Mycoses 2003, 46, 132–136. [Google Scholar] [CrossRef]
- Zoric, N.; Horvat, I.; Kopjar, N.; Vucemilovic, A.; Kremer, D.; Tomic, S.; Kosalec, I. Hydroxytyrosol expresses antifungal activity in vitro. Curr. Drug Targets 2013, 14, 992–998. [Google Scholar] [CrossRef]
- Latté, K.P.; Kolodziej, H. Antifungal effects of hydrolysable tannins and related compounds on dermatophytes, mould fungi and yeasts. Z. Naturforsch. C J. Biosci. 2000, 55, 467–472. [Google Scholar] [CrossRef] [PubMed]
- Foss, S.R.; Nakamura, C.V.; Ueda-Nakamura, T.; Cortez, D.A.; Endo, E.H.; Dias Filho, B.P. Antifungal activity of pomegranate peel extract and isolated compound punicalagin against dermatophytes. Ann. Clin. Microbiol. Antimicrob. 2014, 13, 32. [Google Scholar] [CrossRef]
- Simonetti, G.; Brasili, E.; Pasqua, G. Antifungal activity of phenolic and polyphenolic compounds from different matrices of Vitis vinifera L. against human pathogens. Molecules 2020, 25, 3748. [Google Scholar] [CrossRef] [PubMed]
- Bernini, R.; Mincione, E.; Barontini, M.; Crisante, F. Convenient synthesis of hydroxytyrosol and its lipophilic derivatives from tyrosol or homovanillyl alcohol. J. Agric. Food Chem. 2008, 56, 8897–8904. [Google Scholar] [CrossRef] [PubMed]
- Crupi, P.; Coletta, A.; Milella, R.A.; Perniola, R.; Gasparro, M.; Genghi, R.; Antonacci, D. HPLC-DAD-ESI-MS Analysis of flavonoids compounds in in 5 seedless table grapes grown in Apulian region. J. Food Sci. 2012, 77, C174–C181. [Google Scholar] [CrossRef]
- Wong-Paz, J.E.; Guyot, S.; Aguilar-Zárate, P.; Muñiz-Márquez, D.B.; Contreras-Esquivel, J.C.; Aguilar, C.N. Structural characterization of native and oxidized procyanidins (condensed tannins) from coffee pulp (Coffea arabica) using phloroglucinolysis and thioglycolysis-HPLC-ESI-MS. Food Chem. 2021, 340, 127830. [Google Scholar] [CrossRef]
- Guinea, J.; Meletiadis, J.; Arikan-Akdagli, S.; Muehlethaler, K.; Kahlmeter, G.; Arendrup, M.C.; Subcommittee on Antifungal Susceptibility Testing (AFST) of the ESCMID European Committee for Antimicrobial Susceptibility Testing (EUCAST). EUCAST Definitive Document E.DEF 9.4. Method for the Determination of Broth Dilution Minimum Inhibitory Concentrations of Antifungal Agents for Conidia Forming Moulds. Available online: https://www.eucast.org/fileadmin/src/media/PDFs/EUCAST_files/AFST/Files/EUCAST_EDef_9.4_method_for_susceptibility_testing_of_moulds.pdf (accessed on 10 February 2023).
- Ritz, C.; Baty, F.; Streibig, J.C.; Gerhard, D. Dose-Response Analysis Using R. PLoS ONE 2015, 10, e0146021. [Google Scholar] [CrossRef] [PubMed]

| Extract | Identification | RT (min) | λmax (nm) | [M − H]− (m/z) | mg/g |
|---|---|---|---|---|---|
| OEP | Hydroxytyrosol | 20.6 | 280 | 153 | 138 ± 4.0 |
| Tyrosol | 27.0 | 276 | 137 | 35.0 ± 0.8 | |
| Total polyphenols | 173 ± 5 | ||||
| CSW | Vescalin | 6.9 | 246, 276 sh | 631 | 9.3 ± 0.2 |
| Castalin | 8.8 | 246, 280 sh | 631 | 8.1 ± 0.2 | |
| Pedunculagin I | 11.5 | 258, 378 sh | 783 | 10.0 ± 0.2 | |
| Monogalloyl glucose | 14.1 | 274 | 331 | 3.81 ± 0.08 | |
| Gallic acid | 15.4 | 272 | 169 | 16.2 ± 0.3 | |
| Vescalagin | 18.4 | 245, 280 sh | 933 | 47.6 ± 0.5 | |
| Dehydrated tergallic-C-glucoside | 20.8 | 250, 374 | 613 | 9.3 ± 0.2 | |
| Castalagin | 21.9 | 248, 280 sh | 933 | 97.7 ± 0.9 | |
| Digalloyl glucose | 24.1 | 274 | 483 | 19.6 ± 0.2 | |
| Trigalloyl glucose | 32.4 | 276 | 635 | 20.6 ± 0.2 | |
| Tetragalloyl glucose | 38.0 | 276 | 787 | 7.7 ± 0.1 | |
| Ellagic acid | 39.6 | 254, 370 | 301 | 6.1 ± 0.2 | |
| Pentagalloyl glucose | 40.8 | 274 | 939 | 4.26 ± 0.08 | |
| Total polyphenols | 260 ± 3 | ||||
| PGP | HHDP glucose 1 | 10.4 | slope | 481 | 0.75 ± 0.01 |
| HHDP glucose 2 | 11.1 | slope | 481 | 0.437 ± 0.009 | |
| HHDP glucose 3 | 12.5 | slope | 481 | 0.71 ± 0.01 | |
| Gallic acid | 15.4 | 272 | 169 | 1.25 ± 0.02 | |
| Monogalloyl glucose | 15.5 | 274 | 331 | 0.106 ± 0.005 | |
| α-Punicalin | 17.0 | 258, 378 | 781 | 1.25 ± 0.04 | |
| β-Punicalin | 17.2 | 258, 380 | 781 | 1.32 ± 0.02 | |
| Punicalagin isomer 1 | 18.4 | 258, 378 | 1083 | 6.90 ± 0.09 | |
| Pedunculagin I | 18.7 | 258, 378 sh | 783 | 1.16 ± 0.06 | |
| Punicalagin isomer 2 | 19.6 | 258, 378 | 1083 | 6.91 ± 0.08 | |
| Pedunculagin III | 21.0 | 260, 378 | 933 | 0.69 ± 0.01 | |
| α-Punicalagin | 23.7 | 258, 378 | 1083 | 27.1 ± 0.3 | |
| β-Punicalagin | 25.9 | 258, 380 | 1083 | 58.5 ± 0.6 | |
| Ellagic acid hexoside | 31.7 | 254, 362 | 463 | 2.10 ± 0.08 | |
| Vanoleic acid bilactone | 34.7 | 258, 366 | 469 | 0.45 ± 0.01 | |
| Ellagitannin m/z 951 | 35.9 | 264, 364 | 951 | 1.02 ± 0.02 | |
| Ellagic acid rhamnoside | 37.0 | 254, 360 | 447 | 0.61 ± 0.03 | |
| Ellagic acid pentoside | 37.4 | 254, 362 | 433 | 0.87 ± 0.04 | |
| Ellagic acid | 39.1 | 254, 368 | 301 | 2.60 ± 0.08 | |
| Total polyphenols | 115 ± 2 |
| Extract | Identification | RT (min) | λmax (nm) | [M + H]+ (m/z) | mg/g |
|---|---|---|---|---|---|
| VVP | Delphinidin-3-glucoside | 8.2 | 522 | 465 | 0.262 ± 0.007 |
| Cyanidin-3-glucoside | 9.0 | 514 | 449 | 0.0097 ± 0.0003 | |
| Petunidin-3-glucoside | 9.3 | 524 | 479 | 0.365 ± 0.008 | |
| Peonidin-3-glucoside | 10.6 | 518 | 163 | 0.089 ± 0.003 | |
| Malvidin-3-glucoside | 11.0 | 526 | 493 | 1.30 ± 0.02 | |
| Delphinidin-3-coumaroyl glucoside | 15.8 | 530 | 611 | 0.130 ± 0.004 | |
| Cyanidin-3-acetyl glucoside | 17.6 | 524 | 491 | 0.0100 ± 0.0005 | |
| Petunidin-3-coumaroyl glucoside | 18.0 | 532 | 625 | 0.173 ± 0.005 | |
| Malvidin-3-coumaroyl glucoside | 20.0 | 532 | 639 | 0.80 ± 0.02 | |
| Gallic acid | 16.0 | 272 | 169 [M − H]− | 2.37 ± 0.06 | |
| Procyanidin dimer B3 | 30.6 | 280 | 579 | 7.0 ± 0.2 | |
| Catechin | 33.9 | 280 | 291 | 0.414 ± 0.008 | |
| Procyanidin trimers | 57.4 | 280 | 867 | 2.01 ± 0.05 | |
| Procyanidin dimer B6 | 59.0 | 280 | 579 | 2.85 ± 0.08 | |
| Procyanidin dimer B2 | 64.0 | 280 | 579 | 10.2 ± 0.3 | |
| Epicatechin | 76.5 | 280 | 291 | 0.320 ± 0.008 | |
| Procyanidin trimer | 77.0 | 280 | 867 | 50 ± 2 | |
| Epicatechin gallate dimers | 79.0 | 280 | 883 | 0.85 ± 0.02 | |
| Procyanidin tetramers | 90.9 | 280 | 1155 | 293 ± 4 | |
| Epicatechin gallate dimers | 104.4 | 280 | 883 | 53 ± 1 | |
| Total polyphenols | 425 ± 8 | ||||
| VVS | Gallic acid | 16.0 | 272 | 169 [M − H]− | 1.50 ± 0.02 |
| Procyanidin dimer B3 | 30.6 | 280 | 579 | 26 ± 1 | |
| Catechin | 33.9 | 280 | 291 | 45 ± 1 | |
| Procyanidin trimer | 57.4 | 280 | 867 | 8.8 ± 0.2 | |
| Procyanidin dimer B6 | 59.0 | 280 | 579 | 11.2 ± 0.3 | |
| Procyanidin dimer B2 | 64.0 | 280 | 579 | 13.6 ± 0.3 | |
| Epicatechin | 76.5 | 280 | 291 | 30.3 ± 0.8 | |
| Procyanidin dimers gallate | 88.3 | 280 | 731 | 20.1 ± 0.5 | |
| Procyanidin trimers digallate | 89.7 | 280 | 1171 | 315 ± 9 | |
| Procyanidin tetramers (I) | 90.0 | 280 | 1155 | 54.7 ± 0.16 | |
| Epicatechin gallate | 92.2 | 280 | 443 | 6.24 ± 0.08 | |
| Procyanidin tetramers (II) | 95.0 | 280 | 1155 | 11.6 ± 0.5 | |
| Procyanidin dimers digallate | 98.5 | 280 | 883 | 142 ± 5 | |
| Total polyphenols | 686 ± 20 |
| Extract/Compound | Growth Inhibition (%) at Different Extract Concentration (w/v) | ||
|---|---|---|---|
| 1.0% | 0.5% | 0.1% | |
| OEP | 48.3 ± 2.7 c | 35.8 ± 8.7 bc | 18.2 ± 14.4 c |
| CSW | 100 a | 32.1 ± 7.9 c | 4.7 ± 4.4 c |
| PGP | 100 a | 100 a | 100 a |
| VVP | 62.6 ± 9.9 b | 46.3 ± 13.1 b | 34.7 ± 8.8 b |
| VVS | 17.6 ± 8.0 d | 24.1 ± 1.8 c | 5.0 ± 3.6 c |
| BA | 100 a | 100 a | 100 a |
| SK | 100 a | 100 a | 100 a |
| Sign. code | *** | *** | *** |
| Extract/Compound | Growth Inhibition (%) at Different Extract Concentration (w/v) | ||
|---|---|---|---|
| 1.0% | 0.5% | 0.1% | |
| OEP | No effect | No effect | No effect |
| CSW | 82.0 ± 8.7 b | 83.4 ± 3.7 c | 82.1 ± 5.5 b |
| PGP | 100 a | 92.8 ± 6.6 b | 68.4 ± 6.6 c |
| VVP | 42.0 ± 5.7 c | 7.0 ± 7.9 de | No effect |
| VVS | 13.7 ± 6.2 d | No effect | No effect |
| BA | 100 a | 100 a | 100 a |
| SK | 100 a | 100 a | 100 a |
| Sign. code | *** | *** | *** |
| Extract/Compound | Growth Inhibition (%) at Different Extract Concentration (w/v) | ||
|---|---|---|---|
| 1.0% | 0.5% | 0.1% | |
| OEP | 66.5 ± 2.9 b | 25.3 ± 1.2 b | 14.0 ± 1.0 d |
| CSW | 100 a | 100 a | 100 a |
| PGP | 100 a | 100 a | 100 a |
| VVP | 100 a | 100 a | 45.3 ± 4.9 c |
| VVS | 100 a | 100 a | 52.2 ± 4.9 b |
| BA | 100 a | 100 a | 100 a |
| SK | 100 a | 100 a | 100 a |
| Sign. code | *** | *** | *** |
Disclaimer/Publisher’s Note: The statements, opinions and data contained in all publications are solely those of the individual author(s) and contributor(s) and not of MDPI and/or the editor(s). MDPI and/or the editor(s) disclaim responsibility for any injury to people or property resulting from any ideas, methods, instructions or products referred to in the content. |
© 2023 by the authors. Licensee MDPI, Basel, Switzerland. This article is an open access article distributed under the terms and conditions of the Creative Commons Attribution (CC BY) license (https://creativecommons.org/licenses/by/4.0/).
Share and Cite
Lombardi, A.; Campo, M.; Vignolini, P.; Papalini, M.; Pizzetti, M.; Bernini, R. Phenolic-Rich Extracts from Circular Economy: Chemical Profile and Activity against Filamentous Fungi and Dermatophytes. Molecules 2023, 28, 4374. https://doi.org/10.3390/molecules28114374
Lombardi A, Campo M, Vignolini P, Papalini M, Pizzetti M, Bernini R. Phenolic-Rich Extracts from Circular Economy: Chemical Profile and Activity against Filamentous Fungi and Dermatophytes. Molecules. 2023; 28(11):4374. https://doi.org/10.3390/molecules28114374
Chicago/Turabian StyleLombardi, Andrea, Margherita Campo, Pamela Vignolini, Marco Papalini, Mirco Pizzetti, and Roberta Bernini. 2023. "Phenolic-Rich Extracts from Circular Economy: Chemical Profile and Activity against Filamentous Fungi and Dermatophytes" Molecules 28, no. 11: 4374. https://doi.org/10.3390/molecules28114374
APA StyleLombardi, A., Campo, M., Vignolini, P., Papalini, M., Pizzetti, M., & Bernini, R. (2023). Phenolic-Rich Extracts from Circular Economy: Chemical Profile and Activity against Filamentous Fungi and Dermatophytes. Molecules, 28(11), 4374. https://doi.org/10.3390/molecules28114374

